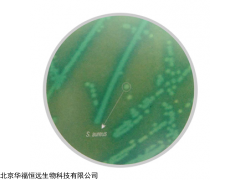

| 提交询价信息 |
| 发布紧急求购 |

价格:电议
所在地:河南 濮阳市
型号:M1931
更新时间:2024-04-16
浏览次数:817
公司地址:北京市朝阳区远洋国际中心
![]()
程艳蕾(女士)
印度HiMedia 金黄色葡萄球菌选择性琼脂
品牌:HiMedia
货号:M1931
规格:500g/瓶
用途:金黄色葡萄球菌的分离和计数

印度HiMedia 金黄色葡萄球菌选择性琼脂 原理
该培养基为选择性显色培养基,可在24小时内对金葡菌分离计数,而传统培养基需48小时。培养基中的酚红为ph指示剂。甘露醇可被金葡菌发酵,显色剂可被金葡菌特异性裂解,产生绿色菌落。表皮葡萄球菌不发酵甘露醇,因而菌落呈现蓝色。培养基中的氯化钠维持渗透压平衡,同时抑制伴随菌群。
配制
103.03g配1L蒸馏水,需高压灭菌。
组成
|
成分 |
g/L |
|
特殊蛋白胨 |
25.000 |
|
氯化钠 |
50.000 |
|
混合显色物 |
3.200 |
|
选择混合因子 |
2.800 |
|
D-甘露醇 |
10.000 |
|
酚红 |
0.025 |
|
琼脂 |
12.000 |
|
最终pH(在25°C时)7.4±0.1 |
|
质量控制
外观:淡黄色至粉色松散粉末。
成胶性:牢固,与1. 2%琼脂凝胶相当。
成品颜色和透明度:红色透明至轻微不透明凝胶。
溶解反应:可形成10.03%w/v水溶液,25°C,pH值7.4±0.2
印度HiMedia 金黄色葡萄球菌选择性琼脂 培养反应
35-37°C培养24-48小时后,观察培养结果。
|
菌株ATCC |
接种量(CFU) |
生长状况 |
回收率 |
菌落颜色 |
|
金黄色葡萄球菌25923 |
50-100 |
旺盛 |
≥50% |
绿色 |
|
金黄色葡萄球菌6538 |
50-100 |
旺盛 |
≥50% |
绿色 |
|
蜡样芽胞杆菌10876 |
≥103 |
抑制 |
0% |
|
|
表皮葡萄球菌12228 |
50-100 |
好 |
40-50% |
蓝色 |
|
粪肠球菌29212 |
≥103 |
抑制 |
0% |
|
|
大肠埃希菌25922 |
≥103 |
抑制 |
0% |
|
即用型培养基
|
货号 |
品名 |
用途 |
包装 |
|
MP1931 |
HiCrome™ Staph Selective Agar Plate,90mm平板 |
金黄色葡萄球菌的分离和计数 |
50块 |
 免责声明:以上所展示的[M1931 印度HiMedia 金黄色葡萄球菌选择性琼脂]信息由会员[北京华福恒远生物科技有限公司]自行提供,内容的真实性、准确性和合法性由发布会员负责。
免责声明:以上所展示的[M1931 印度HiMedia 金黄色葡萄球菌选择性琼脂]信息由会员[北京华福恒远生物科技有限公司]自行提供,内容的真实性、准确性和合法性由发布会员负责。